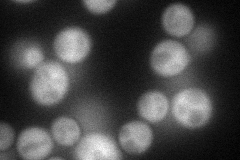
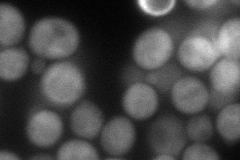
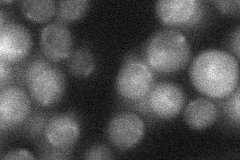
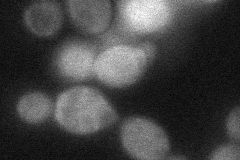
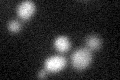
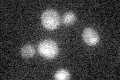

View description
Protein involved in the repair of double-strand breaks in DNA during vegetative growth via recombination and single-strand annealing; anneals complementary single-stranded DNA; homologous to Rad52p
Localization:
Intensity:
Fold change:
Significance:
-
C’ GFP library in SD

below threshold19.67 -
N' NOP1pr-GFP in SD
cytosol72.5955 -
N' TEF2pr-mCherry in SD
cytosol88.4813 -
N' NATIVEpr-GFP in SD
below threshold25.0876 -
N' TEF2pr-VC and Cyto-VN in SD
cytosol44.1365 -
C’ GFP library in SD+DTT
cytosol21.771.1No -
C’ GFP library in SD+H2O2

cytosol16.430.83No -
C’ GFP library in Starvation Media
cytosol18.320.93No -
C’ GFP library on the background of Pup2-DaMP

below threshold -
C’ GFP library on the background of CCT mutant

below threshold19.51980.992136No
